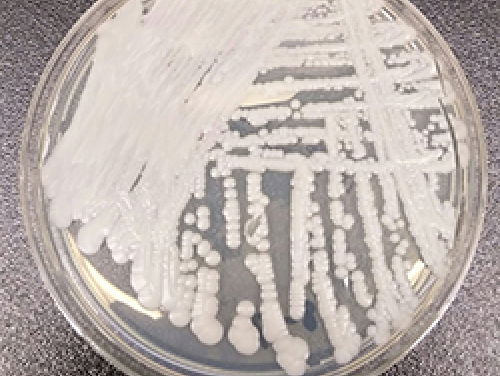
Waarom verspreiden resistente schimmels zich steeds meer?

Fragmenten
Nieuws en Co
- Programma's
- Nieuws en Co
- Fragmenten
- Nieuws en CoNOS/NTR
Waarom verspreiden resistente schimmels zich steeds meer?
- Nieuws en CoNOS/NTR
In Uden mogen toch asielzoekers worden opgevangen
- Nieuws en CoNOS/NTR
Hoe herstel je vertrouwen tussen overheid en burger?
- Nieuws en CoNOS/NTR
Hoe kon derde divisionist Hercules winnen van Ajax?
- Nieuws en CoNOS/NTR
Hoe belangrijk was de sluiting van de Maeslantkering?